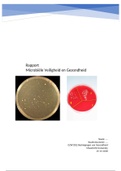
Thumbnail

Microbiële Veiligheid en Gezondheid
Naam: ….
Studentnummer: ….
GZW1022 Bedreigingen van Gezondheid
Maastricht University
25-11-2018
Rapport Practicum Microbiële Veiligheid en Gezondheid GZW1022 Bedreigingen van Gezondheid Maastricht University gezondheidswetenschappen jaar 1 Dit rapport is beoordeeld met een goed en bevat uitwerkingen van interpretatie A en B met conclusies, vragenset 2 en een referentielijst.

Alle beoordelingen zijn geschreven door echte Stuvia-gebruikers na geverifieerde aankopen.
Ik ben afgestudeerd aan de opleiding Gezondheidswetenschappen aan Maastricht University en volgde de richting Biologie en Gezondheid. Op mijn profiel kun je alle documenten, voor een lage prijs, vinden die je nodig hebt om je studie zo goed mogelijk af te ronden. Er staan uitwerkingen van taken, voorbereidingen voor bijeenkomsten, presentaties, verslagen en oefenvragen op mijn profiel. Tevens heb ik bundels van de verschillende blokken en van het volledige 1e, 2e en 3e jaar gemaakt MET 50% KORTING tov originele documenten (inclusief of exclusief FiA documenten). Kijk gerust rond op mijn profiel of er documenten voor je bij zitten en mocht je vragen hebben (algemeen, over de opleiding of over de documenten zelf), kun je mij altijd een berichtje sturen! :)







Kwaliteit die je kunt vertrouwen: geschreven door studenten die slaagden en beoordeeld door anderen die dit document gebruikten.
Geen zorgen! Je kunt voor hetzelfde geld direct een ander document kiezen dat beter past bij wat je zoekt.
Geen abonnement, geen verplichtingen. Betaal zoals je gewend bent via iDeal of creditcard en download je PDF-document meteen.

“Gekocht, gedownload en geslaagd. Zo makkelijk kan het dus zijn.”